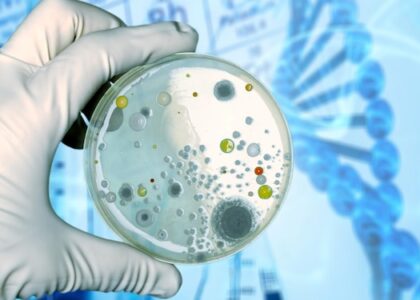

Global Cell Culture Market to Reach USD 44,593.1 Million by 2034, Driven by Biopharmaceutical Demand and Personalized Medicine Advancements | FMI
The global cell culture market is poised for significant growth, with projections estimating a rise

The global cell culture market is poised for significant growth, with projections estimating a rise
As per Future Market Insights (FMI) latest analysis, the global cell culture market is projected
The global cell culture market growth has seen substantial growth and is projected to continue
The global cell culture market is on an upward trajectory, reaching a valuation of US$

The size of the global cell culture market was evaluated at US$ 25.4 billion in 2022 and

The Cell Culture Market is a rapidly growing sector in the life sciences industry that
The Cell Culture Market is a rapidly growing sector in the life sciences industry that

The Cell Culture Market is now a vital resource for scientists and researchers working in
The global Cell Culture Market Size is expected to be worth US$ 25.4 billion in
The global cell culture market size is expected to be worth US$ 25.4 billion in